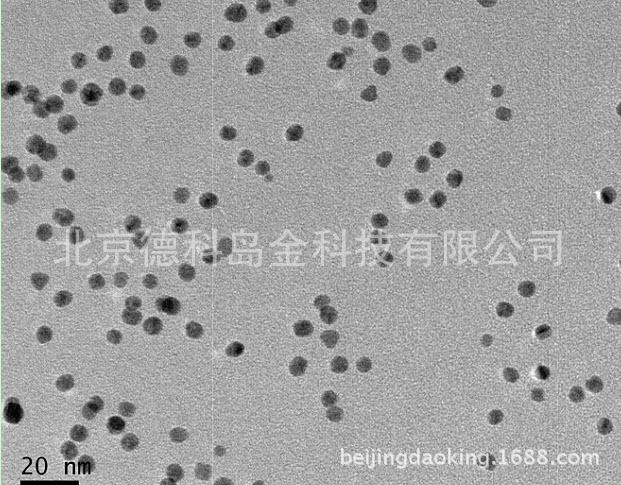
金纳米颗粒纳米金溶液peg化金纳米粒子5nm200nm

金纳米颗粒

球形金纳米颗粒
图片尺寸600x400
各种金纳米颗粒gold nanoparticles
图片尺寸1347x896
不同径粒的金纳米颗粒
图片尺寸1080x1439
例如,就像药物传递的机制一样,金纳米颗粒可以被证明对癌症成像很有用
图片尺寸602x338
材料人评论 | 多孔金属纳米粒子,金属纳米材料未来的一种可能?
图片尺寸330x262
水溶性球形金纳米颗粒aunps,粒径:5nm- 200nm可按需求定制
图片尺寸438x427
金纳米颗粒粉末
图片尺寸586x422
中科科优 peg修饰金纳米颗粒 5nm-200nm 科研级 多规格可选
图片尺寸800x800
水溶性球形金纳米颗粒粒径5nm10nm20nm30nm50nm60nm80nm100nm200nm
图片尺寸513x395
中科科优 水溶性金纳米颗粒 5nm-200nm 科研级 规格全 纳米金胶体
图片尺寸800x672
球形金纳米颗粒-au-nanoparticles
图片尺寸640x640
如何才能得到截角八面体的金纳米颗粒的模型结构
图片尺寸600x570
美国科学家揭示金纳米颗粒微观结构
图片尺寸1085x373
peg化球形金纳米颗粒,金纳米笼,金纳米棒的形貌图
图片尺寸572x358
科学家用金纳米颗粒和姜黄制造抗癌药物
图片尺寸533x400![纳米金的制备与表征[1]ppt](https://i.ecywang.com/upload/1/img1.baidu.com/it/u=2662631906,1664795254&fm=253&fmt=auto&app=138&f=JPEG?w=667&h=500)
纳米金的制备与表征[1]ppt
图片尺寸1080x810
水溶性金纳米粒子5-300nm 尺寸可定制
图片尺寸594x603
科研制图如何用3dsmax挤出工具绘制纳米金星球
图片尺寸2048x2048
金纳米颗粒纳米金溶液peg化金纳米粒子5nm200nm
图片尺寸621x485
纳米金都有哪些金纳米颗粒金纳米粒子金纳米胶体等的颜色和形态
图片尺寸800x911














![纳米金的制备与表征[1]ppt](https://i.ecywang.com/upload/1/img1.baidu.com/it/u=2662631906,1664795254&fm=253&fmt=auto&app=138&f=JPEG?w=667&h=500)


















![纳米金的制备与表征[1]ppt](https://www.51wendang.com/pic/45da5ca74bb14b41156d712b/2-810-jpg_6-1080-0-0-1080.jpg)